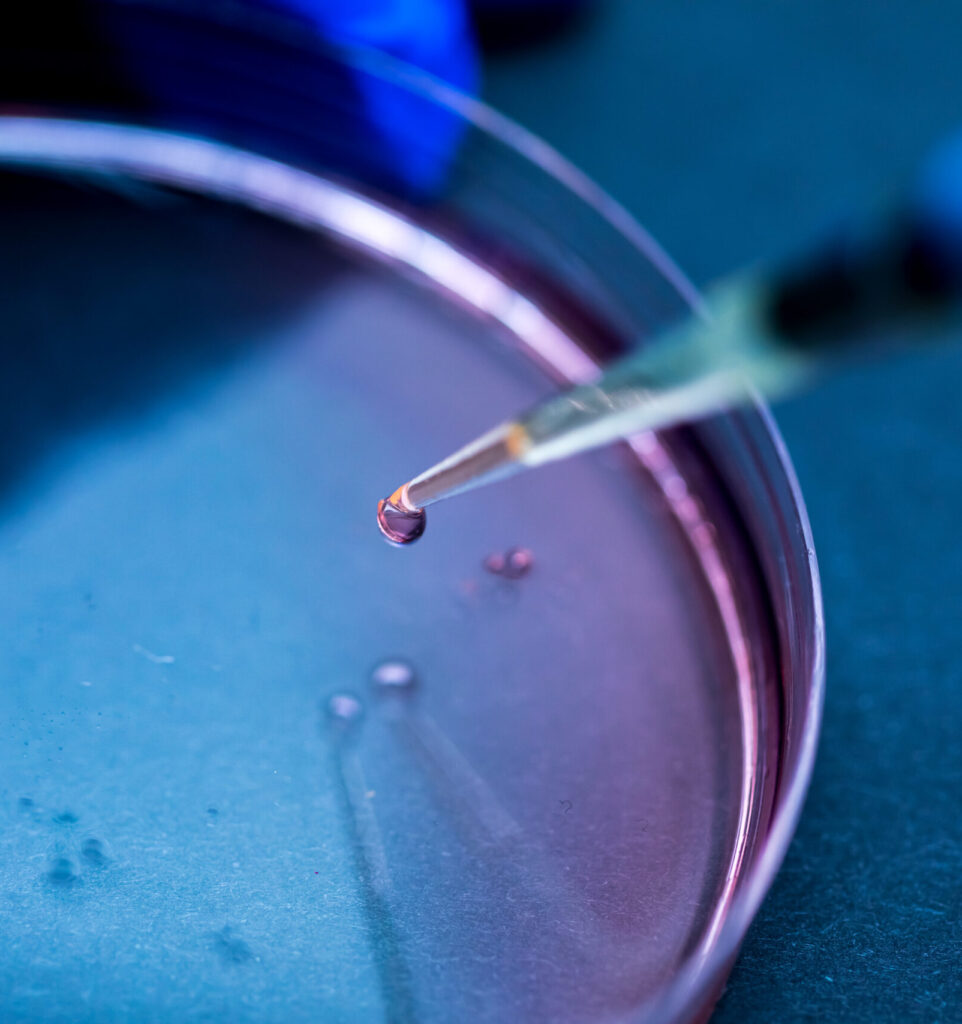

تحوّل هيومن لينك الأدلة إلى أثر ملموس، من خلال تعزيز النظم وتوجيه النتائج الصحية على المستويين الإقليمي والعالمي.
هيومن لينك هي مؤسسة بحث وتطوير ملتزمة بتعزيز الصحة العالمية من خلال العلم والابتكار والتعاون بين القطاعات المختلفة.
نختص بالبحوث التطبيقية، وترصد مسببات الأمراض، والاستجابة لتفشي الأوبئة، وعلوم المختبرات، وبناء القدرات، وتطوير السياسات، مع التركيز على معالجة التهديدات الصحية من جذورها وتعزيز النظم حيث يكون التأثير الأكبر.
نعمل في أكثر من 20 دولة، ويتعاون فريقنا متعدد التخصصات مع الوزارات والمؤسسات الأكاديمية والوكالات الدولية لمواجهة التحديات الصحية المعقدة من خلال حلول عملية قائمة على الأدلة.
النهوض بالأمن الصحي العالمي من خلال تعزيز البحث العلمي، وتطوير الانظمة الصحية، وتشجيع التعاون متعدد التخصصات عبر قطاعات صحة الإنسان والحيوان والبيئة. ومن خلال الابتكار والشراكات الاستراتيجية والمشاركة في تطوير السياسات، نعمل على بناء انظمة شاملة وقابلة للتكيّف ومستدامة تحمي الصحة وتعزّز الصمود على جميع المستويات.
المساهمة في بناء بنية صحية عالمية منسّقة، تسهم فيها النظم القوية، والسياسات المبنية على الأدلة، والتعاون متعدد القطاعات في دعم التنمية المستدامة، وصون صحة المجتمع والثروة الحيوانية والأنظمة البيئية.
تعمل هيومن لينك من خلال فريق متعدد التخصصات في مجالات العلوم الطبية الحيوية، والصحة العامة، والعلوم البيئية، والعلوم الاجتماعية، والتنمية البشرية، والهندسة.
كما تشمل شبكة من المستشارين والمتعهدين والشركاء الذين يقدّمون خبرات متخصصة عند الحاجة. ويسمح هذا الهيكل المتكامل لهيومن لينك بتنفيذ مشاريع معقّدة وعالية الأثر بكفاءة وعلى نطاق واسع.
يُدار قسم المختبرات من قبل طاقم عمل ذوي خبرة عالية، بدعم من باحثين ومساعدين، وضباط السلامة الحيوية، وفنيي المختبر. نستخدم تقنيات ومنهجيات متقدمة لضمان نتائج عالية الجودة.
تتألف فرق العمليات الميدانية من أطباء بيطريين، ومتخصصون في علم الحيوان، وأطباء، وممرضين يمتلكون خبرة مباشرة في الترصد الوبائي، والاستجابة لتفشي الأمراض، والدراسات الوبائية في ظروف عمل صعبة.
يقدّم فريق التدريب وبناء القدرات برامج متخصصة وورش عمل تطبيقية وتمارين محاكاة ودورات “تدريب المدربين”. تشمل خبراتهم التشخيص الجزيئي، والسلامة الحيوية، والاستعداد لتفشي الأمراض، وعلم الأوبئة الميداني، وتعزيز الانظمة الصحية، مما يضمن نقل المعرفة بفعالية إلى الشركاء المحليين.
يتم توفير الدعم الإداري والتشغيلي من قبل فريق متخصص يتولى إدارة المشاريع، والخدمات اللوجستية، والمالية، والامتثال، والاتصالات، مما يسهّل تنفيذ المشاريع بكفاءة والتنسيق مع أصحاب المصلحة.
نلتزم بأعلى معايير أخلاقيات البحث وجودة البيانات وإنتاج الأدلة لدعم اتخاذ القرارات الصحية على جميع المستويات.
نعمل عبر التخصصات والقطاعات والحدود لمعالجة التحديات الصحية المعقدة، ونطوّر حلولًا مشتركة بالتعاون مع الحكومات والجامعات والشركاء الدوليين.
نتبنّى أحدث الأدوات والتقنيات والأفكار لتسريع الاكتشاف وتحويل المعرفة إلى عمل فعّال.
ننطلق من فهم شامل بأن صحة الإنسان والحيوان والبيئة مترابطة وتتطلب حلولًا متكاملة
نركّز على تقديم نتائج ملموسة ومستدامة تعزّز الانظمة الصحية، وتحسن الأمن الصحي، وتدعم الصحة العالمية.